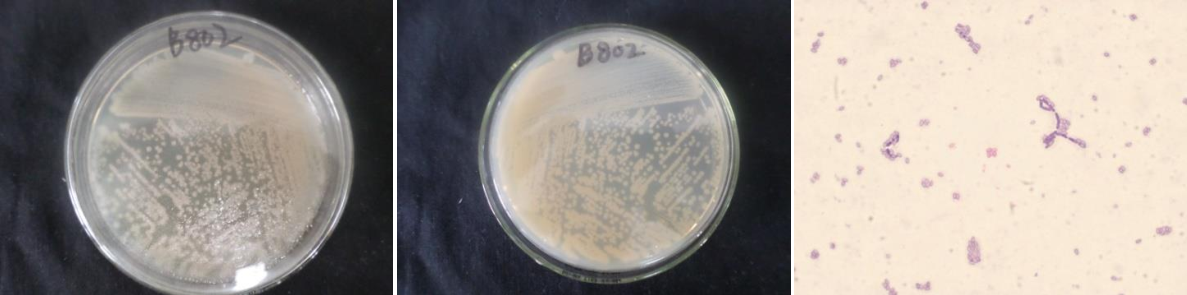

Loading...
| StrainNO | B802 |
| Classification | Bacillus |
| 16s rDNA sequence | ATGCAGTCGAGCGGAGTTTTGAAAAGCTTGCTTTTCAAAACTTAGCGGCGGACGGGTGAGTAACACGTGGGCAACCTGCCCTTG AGACGGGGATAACTCCGGGAAACCGGAGCTAATACCGGATAACACATATCTTCGCATGAGGATATGTTAGAAGGTGGCTTTTAG CTACCACTCAAGGATGGGCCCGCGGCGCATTAGCTAGTTGGTGAGGTAACGGCTCACCAAGGCGACGATGCGTAGCCGACCTGA GAGGGTGATCGGCCACACTGGGACTGAGACACGGCCCAGACTCCTACGGGAGGCAGCAGTAGGGAATCTTCCGCAATGGACGAA AGTCTGACGGAGCAACGCCGCGTGAGTGATGAAGGTTTTCGGATCGTAAAGCTCTGTTGTTAGGGAAGAACAAGTACCTGTTGA ATAAGCAGGTACCTTGACGGTACCTAACCAGAAAGCCACGGCTAACTACGTGCCAGCAGCCGCGGTAATACGTAGGTGGCAAGC GTTGTCCGGAATTATTGGGCGTAAAGCGCGCGCAGGCGGTTCCTTAAGTCTGATGTGAAAGCCCACGGCTCAACCGTGGAGGGT CATTGGAAACTGGGGAACTTGAGTGCAGAAGAGGAGAGCGGAATTCCACGTGTAGCGGTGAAATGCGTAGAGATGTGGAGGAAC ACCAGTGGCGAAGGCGGCTCTCTGGTCTGTAACTGACGCTGAGGCGCGAAAGCGTGGGGAGCGAACAGGATTAGATACCCTGGT AGTCCACGCCGTAAACGATGAGTGCTAAGTGTTAGAGGGTTTCCGCCCTTTAGTGCTGCAGCAAACGCATTAAGCACTCCGCCT GGGGAGTACGGTCGCAAGACTGAAACTCAAAGGAATTGACGGGGACCCGCACAAGCGGTGGAGCATGTGGTTTAATTCGAAGCA ACGCGAAGAACCTTACCAGGTCTTGACATCCTCTGCTACTTCTAGAGATAGAAGGTTCCCTTCGGGGACAGAGTGACAGGTGGT GCATGGTTGTCGTCAGCTCGTGTCGTGAGATGTTGGGTTAAGTCCCGCAACGAGCGCAACCCTTGATCTTAGTTGCCAGCATTT AGTTGGGCACTCTAAGGTGACTGCCGGTGACAAACCGGAGGAAGGTGGGGATGACGTCAAATCATCATGCCCCTTATGACCTGG GCTACACACGTGCTACAATGGATGGTACAAAGGGCTGCAAAACCGCGAGGTTAAGCCAATCCCATAAAACCATTCTCAGTTCGG ATTGTAGGCTGCAACTCGCCTACATGAAGCCGGAATCGCTAGTAATCGCGGATCAGCATGCCGCGGTGAATACGTTCCCGGGTC TTGTACACACCGCCCGTCACACCACGAGAGTTTGTAACACCCGAAGTCGGTGAGGTAACCTTTTGGAGCCAGCCGCCG |
| Strain Morphology Photos | |
| Morphological Description | Colony round;clam white;edge serrated;edge bumps;Many wrinkles;slippy;sticky;waxy;strain:Rod;having spore;Spores are intermediate |